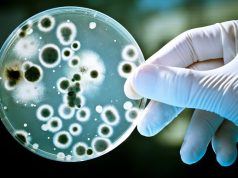
În pandemie, românii au fost tratați „cam arogant”, ca organisme, nu ca oameni cu nevoi

Mihaela Cuțui este medic stomatolog în Timișoara din 1998. Sunt ani de când încearcă să determine o schimbare în sistemul medicinei stomatologice, cotropite de un grup care ia decizii peste capul profesioniștilor, potrivit PRESShub.
Colegiul Medicilor Stomatologi din România (CMSR) este acaparat de o conducere care dispune fără transparență de profesie, ne spune interlocutoarea. Și aduce dovezi.
„Am ajuns o oaie neagră”, mi-a mărturisit doamna doctor.
Solidaritatea de breaslă este timidă, fiindcă aceleași persoane se află la butoane atât la CMSR, cât și în organismele care decid carierele universitare în domeniu. Oamenii se tem.
În Timișoara, au apărut în 2019 și recent afișe lipite pe stâlpi cu titlul „#Stop Corupției din Stomatologie în UMF Timișoara.#Șpăgarii în euro”, care denunță corupția din sistemul universitar, cu tarife înscrise în dreptul unor profesori: BC 2.500 euro, SC 1.300 euro, NM 1.300 euro, PM 300 euro, TA 150 euro.

Numele apar explicit pe afișele atribuite studenților.
Concluzia amară a Mihaelei Cuțui este că „societatea românească nu este pregătită pentru a semnala abuzul fără frică”.
Iar bătălia dusă de societatea civilă și de organismele europene pentru a împiedica mutilarea prevederilor legale privind avertizorul de integritate și abuzul în serviciu în favoarea abuzatorilor este departe de sfârșit în România.
PRESShub: Ce v-a determinat să deveniți avertizor de integritate, doamnă doctor?
Mihaela Cuțui: Când am început să semnalez neregulile din sistemul medical stomatologic, nici nu știam de Legea 571/2004 și nici că aș fi avertizor de integritate. Aceste informații mi-au parvenit mult mai târziu. Pe mine ca și pe mulți din colegii mei, ne-au nemulțumit felul în care se iau decizii de sus în numele profesiei, dar fără practicienii stomatologi. Vă explic.
A apărut în 2017 Legea 185 care conferea atribuții de control Autorității Naționale în Managementul Calității în Sănătate (ANMCS), inclusiv asupra medicinei de ambulator din care face parte și medicina dentară. Această autoritate a ajuns prin lege să obțină bani de la bugetul statului iar directorul acestei autorități are rang de secretar de stat.
Autoritatea este construită pe scheletul fostului CONAS, Comisia Națională de Acreditare a Spitalelor și verifică managementul calității în sănătate. Doar unitățile care îndeplinesc standardele impuse pot funcționa. De când există CONAS și succesorul său n-am văzut ca spitalele să se fi modernizat după standarde și nici să fie oprite să funcționeze dacă nu le îndeplinesc.
De altfel, aceste standarde inspirate de cele americane, australiene, canadiene etc. încep să fie contestate de europeni. Practic, acest ANMCS ar grăbi falimentul firmelor mici, dacă ar impune standardele neadecvate sistemului nostru și ar duce la corporalizare, așa cum s-a întâmplat cu farmaciile.
Ce a zis guvernul la aceste mișcări?
Mișcarea a început de la medicina de familie, unde medicii sunt foarte bine organizați și au făcut presiuni la organizațiile profesionale și patronale, presiuni la care s-au aliat și unele colegii teritoriale de la noi, stomatologii.
În februarie 2018 au existat niște întâlniri privind implementarea sistemului cu directorul ANMCS, ministru secretar de stat, care pe atunci era Vasile Cepoi.
A apărut la discuție și întrebarea „Dar Stomatologia unde este?”. Iar răspunsul lui a fost „Cu Stomatologia am bătut palma”.
Ce a vrut să spună directorul ANMCS?
A spus adevărul, că s-a bătut palma nu cu medicii practicieni, ci cu conducerea națională, cu Colegiul Medicilor Stomatologi din România (CMSR), care a luat o decizie fără transparență și fără să se consulte cu medicii stomatologi. Și de aici a început totul.
Care este sistemul de organizare la nivelul medicinei dentare?
Noi suntem organizați pe principiul ONG-urilor. Există colegiile teritoriale, care se constituie independent, cu CIF separat fiecare, conform Legii 95/2006, iar la nivel național există o structură care ar trebui să articuleze doleanțele medicilor practicieni din teritoriu cu autoritățile guvernamentale. Practic, acest lucru nu se întâmplă.
La ora actuală, din cauza modificării Legii 95 prin Legea 308/2022 practic am devenit o organizație profesională de tip feudal.
Acest lucru s-a realizat cu niște „inginerii” șmecherești cu sprijinul unor persoane din Ministerului Sănătății care au promovat o Ordonanță de Urgență, trecută prin Comisiile Senatului și ale Camerei Deputaților fără să țină cont de amendamentele depuse de medici și de Colegiile teritoriale.
„Toți medicii stomatologi care doresc să exercite profesia pe teritoriul României sunt obligați prin lege să devină membri ai Colegiului Medicilor Stomatologi din România sau să dețină un aviz de practică temporară sau ocazională, având drepturile și obligațiile stabilite conform legii și deciziilor organelor de conducere a corpului profesional” (Legea 95/2006)
În ce a constat „ingineria”?
Ingineria a constat că modificările legii 95 a fost lipită de programul de cancer. Înțelegeți deci că OUG care se referea la programul de cancer i s-a adăugat modificări la Legea 95 care nu aveau legătură cu cancerul. Modificările au vizat reducerea autonomiei Colegiilor teritoriale, CMSR primind dreptul de a dizolva orice colegiu dorește.
Ce puteri în plus îi conferea Colegiului Național Ordonanța?
Practic nu mai trebuia să răspundă în fața nimănui, deciziile Biroului Executiv sunt secrete, toate deciziile Consiliului Național devin secrete, deci un medic practician a ajuns printr-o ordonanță să fie obligat să fie înscris în această organizație de drept privat pentru a putea practica în România.
Dar pentru cotizația pe care o plătește nu are niciun drept decât să execute orbește deciziile Colegiului. Iar dacă îndrăznești să ai o opinie contrară, în afara faptului că s-a scos medierea de la Comisiile de disciplină, poți să fii sancționat cu niște amenzi care, dacă nu sunt plătite Colegiului, ți se poate ridica dreptul de liberă practică.
Cred că președinta CMSR, doamna Ionescu, a exprimat cel mai bine ce putere are la Craiova: „Eu sunt Putin în stomatologia românească”.
Cum se plătește cotizația, teritorial sau central?
Din cotizația plătită de fiecare membru înscris la filiala teritorială 25% merge la Centru, la conducerea națională, conform Legii 95. Structura națională beneficiază de 1,4 milioane euro pe an, pentru care nu dă socoteală nimănui.
Menționez că avem proces câștigat pentru procesele verbale ale ședințelor Colegiului Național și ale Adunării Generale naționale, precum și datele contabile care trebuia să ne fie predate în analitic, defalcate pe capitole -cheltuieli, venituri etc. pe perioada 2015-2019.
Eu personal am dat în judecată, sprijinită de colegiul teritorial. Am cerut deci execuția bugetară. Nu a existat transparență în nicio decizie, iar această conducere națională a trădat profesia. Persoanele din conducere a acaparat profesia, atât zona practicienilor, cât și zona universitară.
E vorba de Ionescu Ecaterina, președintă, Bucur Alexandru, Brezoescu Alexandru, Forna Norina, Câmpeanu Radu și Olteanu Mia.
„Colegiul Medicilor Stomatologi din România este organism profesional, apolitic, fără scop lucrativ, de drept public, cu responsabilități delegate de autoritatea de stat, în domeniul autorizării, controlului și supravegherii profesiei de medic dentist ca profesie liberală, de practică publică autorizată, având autonomie instituțională în domeniul său de competență, normativ și jurisdicțional profesional”. (Legea 95/2006)
Continuare în PRESShub!